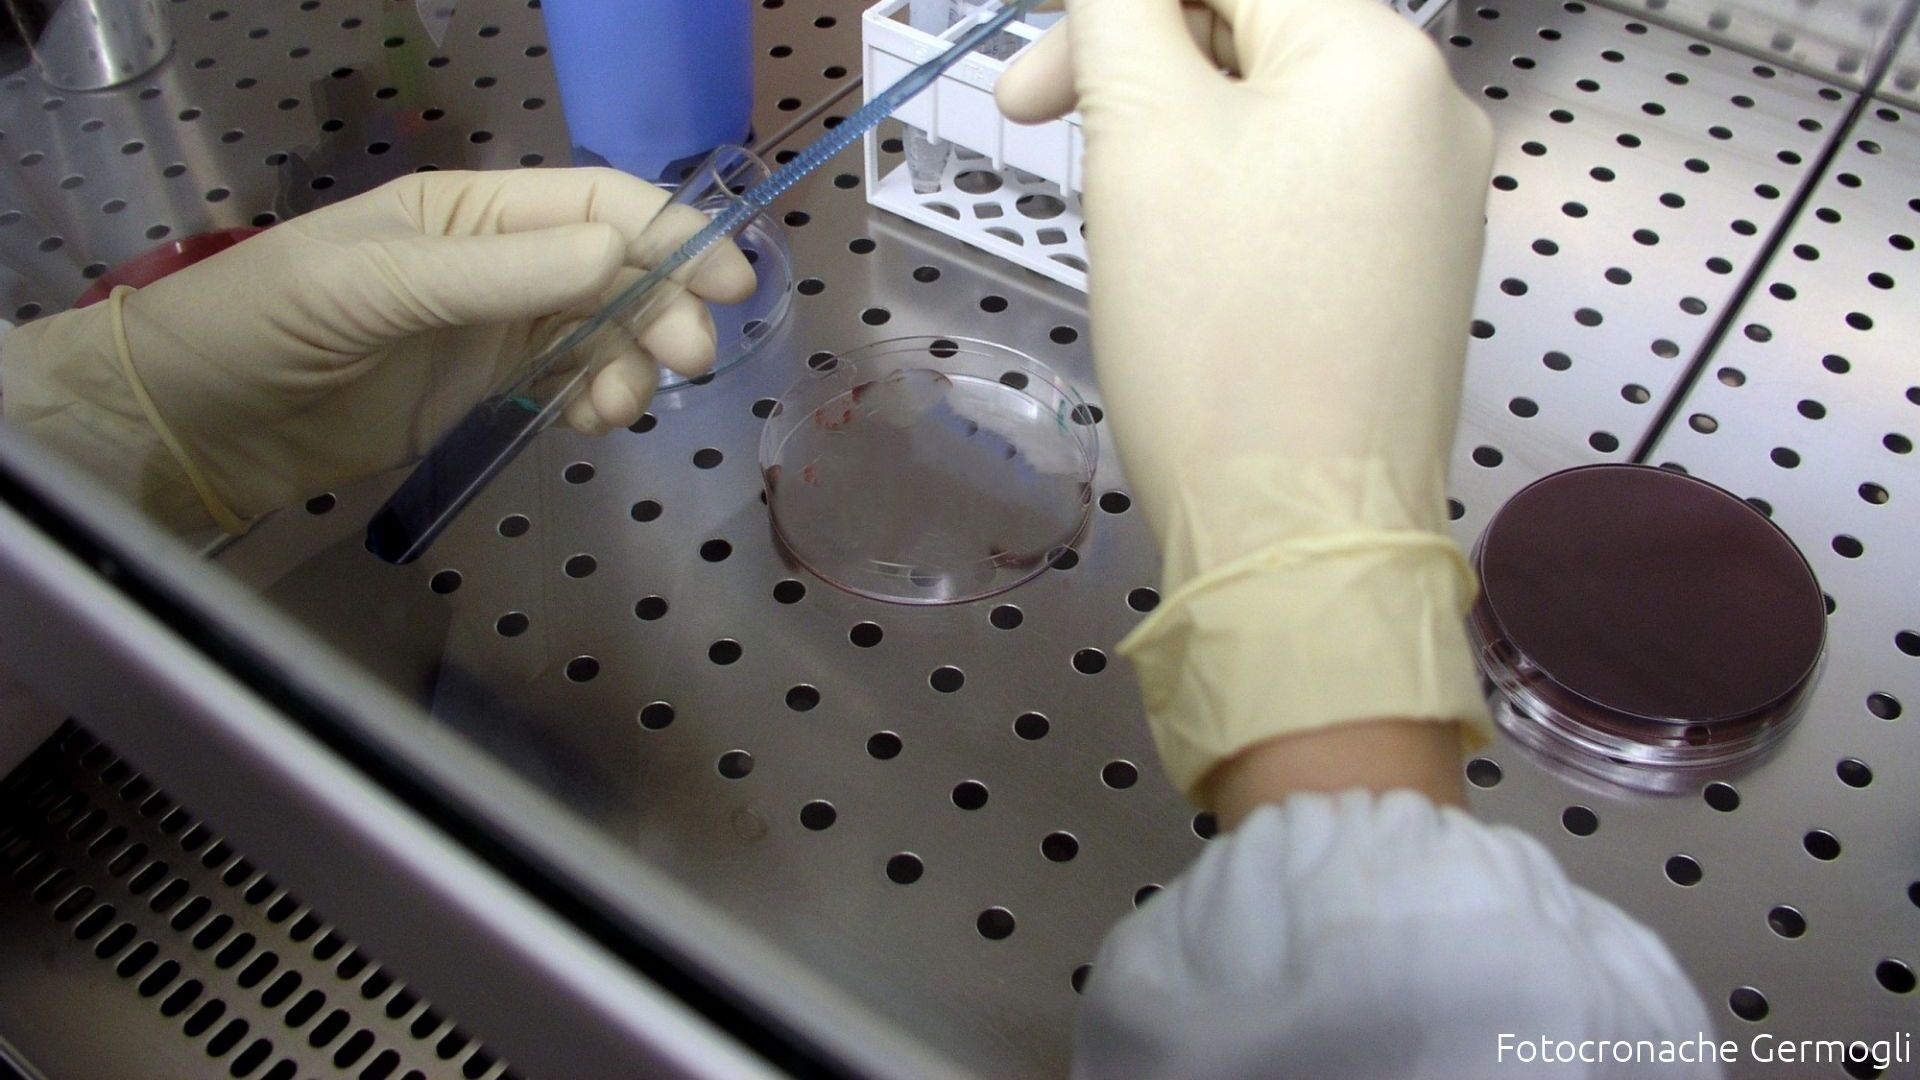

Caso di influenza aviaria in un allevamento a Campi Bisenzio: soppressi mille volatili in circa 12 ore
Accertamenti sanitari sui lavoratori dell’azienda, attualmente sottoposti a sorveglianza attiva a scopo precauzionale
mercoledì 25 marzo 2026 17:34
Un caso di influenza aviaria è stato registrato a Campi Bisenzio in un allevamento di volatili, in parte destinati alla macellazione e in parte al ripopolamento per scopi venatori.
Lo si apprende dall'Asl Toscana Centro, che spiega che "gli animali, circa un migliaio, sono stati tutti abbattuti nel giro di circa 12 ore dalla comunicazione arrivata alla Sanità Pubblica Veterinaria e Sicurezza Alimentare di Asl Toscana centro, con un intervento tempestivo che ha impegnato le autorità veterinarie in un ingente operazione per garantire la sicurezza sanitaria. La notifica è stata trasmessa agli operatori venerdì pomeriggio dal centro di referenza nazionale dell’Istituto Zooprofilattico Sperimentale di Padova dove erano stati portati i campioni prelevati dall’Azienda Usl Toscana centro a seguito di segnalazione della Usl di Perugia che aveva diagnosticato un focolaio di influenza aviara nell’allevamento da cui provenivano i volatili giunti a Campi".
"I veterinari di Asl hanno compiuto nello stesso pomeriggio di venerdì gli accertamenti sul posto e anche se nessun animale riportava sintomi clinici, hanno proceduto a fare i tamponi faringei e a inviarli in laboratorio. Alle 13.30 del sabato sono arrivati da Padova i risultati delle analisi: uno dei tamponi è risultato positivo al virus dell’influenza aviaria. Nel pomeriggio di sabato 21 marzo, in conformità alle normative vigenti, si è proceduto all’abbattimento sul posto di tutti i volatili presenti nell’allevamento. È poi stata istituita una zona di sorveglianza con un raggio di 10 km, all’interno della quale si applicano misure restrittive sulla movimentazione degli animali e una zona di protezione più ristretta, estesa per 3 km".
"A scopo precauzionale, contestualmente a queste operazioni sull’allevamento, in collaborazione con il Servizio di Igiene Pubblica competente per territorio, sono stati avviati tempestivi accertamenti sanitari sui lavoratori dell’azienda. In attesa dei risultati, sono attualmente sottoposti a sorveglianza attiva".
"Preme sottolineare la natura puramente precauzionale di tali misure: sulla base delle evidenze disponibili, il passaggio del virus dell’influenza aviaria all’uomo è un evento estremamente raro e in Italia, ad oggi, non si sono mai registrati casi di trasmissione all’uomo del virus in questione. Per questo da parte degli operatori del Servizio di Igiene Pubblica l’atteggiamento è di moderata tranquillità, accompagnato da un attento monitoraggio della situazione e dall’applicazione scrupolosa delle misure di prevenzione", conclude l'azienda sanitaria.